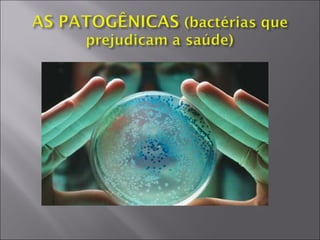

O documento descreve as principais características e classificações das bactérias e arqueas, incluindo sua estrutura celular, tamanho, importância ecológica e econômica, e papel em processos como decomposição, ciclo do nitrogênio e doenças. Também discute a classificação dessas células procarióticas nos reinos Monera, Bacteria e Archaea.